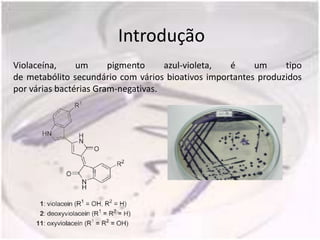
Introdução
Violaceína,     um      pigmento     azul-violeta, é     um     tipo
de metabólito secundário com vários bioativos importantes produzidos
por várias bactérias Gram-negativas.
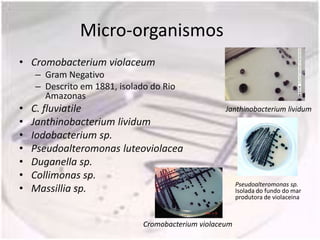
Micro-organismos
• Cromobacterium violaceum
    – Gram Negativo
    – Descrito em 1881, isolado do Rio
      Amazonas
•   C. fluviatile                                   Janthinobacterium lividum
•   Janthinobacterium lividum
•   Iodobacterium sp.
•   Pseudoalteromonas luteoviolacea
•   Duganella sp.
•   Collimonas sp.
                                                         Pseudoalteromonas sp.
•   Massillia sp.                                        Isolada do fundo do mar
                                                         produtora de violaceina



                              Cromobacterium violaceum
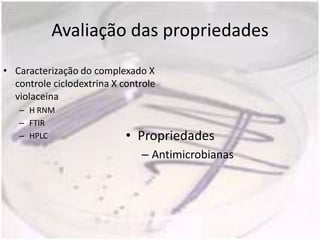
Avaliação das propriedades
• Caracterização do complexado X
  controle ciclodextrina X controle
  violaceina
   – H RNM
   – FTIR
   – HPLC                   • Propriedades
                               – Antimicrobianas

O documento descreve a produção, purificação e complexação da violaceína, um pigmento produzido por bactérias marinhas, com β-ciclodextrina para obtenção de fármacos. A violaceína é produzida por bactérias como Cromobacterium violaceum via quorum sensing e possui propriedades antimicrobianas e anticancerígenas. O documento detalha os métodos para isolamento das bactérias produtoras a partir de amostras marinhas, produção, purificação da violaceína e sua complexa